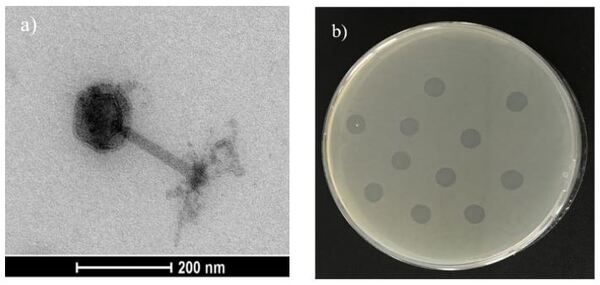

Autofagos: una medida para el control de Salmonella en Avicultura
Salmonella spp. es uno de los principales patógenos causantes de toxiinfecciones alimentarias en Europa y mayoría de países industrializados. Los últimos datos publicados por la EFSA, recogen un total de 94.530 casos de salmonelosis humana en 2016, siendo los productos avícolas la principal fuente de infección. Para el control de la bacteria, además del Plan Nacional de Control de Salmonella, se han implantado rigurosos protocolos de bioseguridad y profilaxis. Sin embargo, en el último año la presencia de Salmonella Enteritidis, principal serotipo causante de las toxiinfecciones alimentarias, ha aumentado en gallina ponedora. Por este motivo, diversos grupos de investigación están estudiando alternativas para de control de Salmonella a nivel de campo, como el empleo de estrategias nutricionales o de bacteriófagos. Los bacteriófagos o fagos son virus que infectan a las células procariotas hasta producir su lisis. La principal aplicación es a través de cócteles que contengan 2 o más bacteriófagos, sin embargo, se han reportado resistencias. En este sentido, está descrita la posibilidad de emplear autofagos (fagos aislados directamente del mismo medio donde se encuentra la bacteria diana) frente a las cepas de campo cuando los cócteles ya no son eficaces, siendo más efectivo que un bacteriófago convencional comercial. En este contexto, el objetivo del estudio fue evaluar la aplicación experimental de los autofagos para el control de S. Enteritidis en gallina ponedora. El estudio se llevó a cabo en una nave experimental cuyo estatus sanitario reveló presencia de S. Enteritidis. Se aisló y fenotipó el autofago a partir de muestras ambientales tomadas de la misma nave donde se aisló la cepa y posteriormente fue aplicado para evaluar su efecto como herramienta de control de Salmonella. Se aplicó vía spray sobre los animales y sobre las superficies de la nave en dos tiempos separados por 24h. Se analizaron un total de 48 muestras (40 muestras de heces y 8 muestras de paños) tomadas en 4 sesiones de muestreo diferentes. Las muestras de paños tomadas previa aplicación del autofago dieron resultado de presencia de Salmonella, sin embargo, tras la primera aplicación del autofago, el 100% de las muestras de paños dieron ausencia a Salmonella. Por lo que respecta a las muestras de heces, se obtuvieron diferencias estadísticamente significativas entre los resultados obtenidos antes (2.34log10 UFC/g) y después (1.07log10 UFC/g) de la aplicación del autofago. Este estudio pone en evidencia que los autofagos se podrían emplear como medida complementaria en la limpieza y desinfección de las instalaciones con una gran eficacia y para reducir los recuentos de Salmonella en animales infectados. Además, el hecho de que el autofago eliminara la Salmonella del medio ambiente, aún con los animales en el interior de la nave, podría evitar la re-contaminación horizontal entre animales.
Palabras clave: Salmonella Enteritidis; autofago; gallina ponedora; in-vivo



- ADHIKARI, PA., COSBY, D.E., COX, N.A., LEE, J.H., and KIM W.K. 2017. Effect of dietary bacteriophage supplementation on internal organs, fecal excretion, and ileal immune response in laying hens challenged by Salmonella Enteritidis. Poult. Sci. 96:3264-3271.
- AHMADI, M., AMIR KARIMI TORSHIZI, M., RAHIMI, S., and DENNEHY, J.J. 2016. Prophylactic Bacteriophage administration more effective than post-infection Administration in Reducing Salmonella enterica serovar Enteritidis shedding in quail. Frontiers Microb. 7: 1253.
- ANDERSON, P.N., HUME, M.E., BYRD, J.A., HERNANDEZ, C., STEVENS, S.M., STRINGFELLOW, K., and CALDWELL, D.J. 2010. Processing, products and food safety. Poult Sci. 89:2030-2037.
- ATTERBURY, R. J., DILLON, E., SWIFT, C., CONNERTON, P.L., FROST, J.A., DODD, C.E.R., REES, C.ED., and CONNERTON, I.F. 2007. Correlation of Campylobacter bacteriophage with reduced presence of hosts in broiler chicken ceca. Appl Environ Microbiol. 71:4885-4887.
- BORIE, C., SANCHEZ, M.L., NAVARRO, C., RAMÍREZ, S., MORALES, M.A., RETAMALES, J., and ROBESON, J. 2009. Aerosol spray treatment with bacteriophages and competitive exclusion reduces Salmonella enteritidis infection in chickens. Avian Dis. 53:250- 254.
- CARVALHO, C., GANNON, M., HALFHIDE, D.E., SANTOS, S.B., HAYES, C.M., ROE, J.M., and AZEREDO, J. The in vivo efficacy of two administrations routes of a phage cocktail to reduce numbers of Campylobacter coli and Campylobacter jejuni in chickens. 2010. BCM. Microbio. 10:232.
- DRULIS-KAWA, Z., MAJKOWSKA-SKROBEK, G., B. MACIEJEWSKA, B., DELATTRE, A. S., and LAVIGNE, R. 2012. Learning for bacteriophages-Advantages and Limitations of phage and phage-encoded protein applications. Curr Protein Pept Sci. 13:699-722.
- EFSA (European Food Safety Authority) and ECDC (European Centre for Disease Prevention and Control), 2017. The European Union summary report on trends and sources of zoonoses, zoonotic agents and food-borne outbreaks in 2016. EFSA Journal 2017;15(12):5077, 228 pp. https://doi.org/10.2903/j.efsa.2017.5077.
- European Centre for Disease Prevention and Control and the European Food Safety Authority. Multi-country outbreak of Salmonella Enteritidis phage type 8 MLVA type 2-9-7-3- 2 and 2-9-6-3-2 infections, 7 March 2017. ECDC and EFSA: Stockholm and Parma; 2017.
- FIFE, M.S., HOWELL, J.S., SALMON, N., HOCKING, P.M., VAN DIEMEN, P.M., JONES, M.A., STEVENS, M.P., and KAISER, P. 2010. Genome-wide SNP analysis identifies major QLT for Salmonella colonization in the chicken. Anim Genet. 42:134-140.
- FILHO, R.A.C.P., BOLDRIN DE PAVAIA, J., DA SILVA, M.D., DE ALMEIDA, A.M., and JUNIOR, A.B. 2010. Control of Salmonella Enteritidis and Salmonella Gallinarum in birds by using live vaccine candidate containing attenuated Salmonella Gallinarum mutant strain. Vaccine. 28:2853-2859.
- FILHO, R. HIGGINS, L., HIGGINS, J.P., GAONA, S.E., WOLFENDEN, A.D., TELLEZ, G., and HARGIS, B.M. 2007. Ability of bacteriophages isolated from different sources to reduce Salmonella enterica serovar enteritidis in vitro and in vivo. Poult Sci. 86:1904-1909.
- FRAVALO, P.H., HASCOET, Y., LE FELLIC, M., QUEGUMER, S., PETTON, J., and SALVAT, G. 2003. Convenient method for rapid and quantitative assessment of Salmonella enteric contamination: the mini-MSRV MPN technique. J Rapid Methods Autom Microbiol. 11:81-88.
- HUFF, W.E., HUFF, G.R., RATH, N.C., BALOG, J.M., and DONOGHUE, A.M. 2003. Evaluation of aerosol spray and intramuscular injection of bacteriophage to treat an Esherichia coli respiratory infection. Poult. Sci. 82:1108-1112.
- ISO 6579-1:2017 (Annex D). 2017. Microbiology of food and animal feeding stuffs. Horizontal method for the detection of Salmonella spp. International Organization for Standardization. Genève, Switzerland.
- KIM, K.H., LEE, G.Y., JANG, J.C., KIM, J.E., and KIM, Y.Y. 2013. Evaluation of anti-SE bacteriophage as feed additives to prevent Salmonella Enteritidis (SE) in broiler. AsianAustralasian. J. Anim. Sci. 26:386-393.
- SEVILLA-NAVARRO, S., MARÍN, C., CORTÉS, V., GARCÍA, C., and CATALÁGREGORI, P. 2018. Autophage as a control measure for Salmonella in laying hens. Poult. Sci. 0:1-6.
- SILVA, M. 2012. Classical Labeling of Bacterial Pathogens According to Their Lifestyle in the Host: Inconsistencies and Alternatives. Front Microbiol. 29:71.
- WANG, S., PHILLIPPY, A.M., DENG, K., RUI, X., LI, Z., TORTORELLO, M. L., and ZHANG, W. 2010. Transcriptomic Responses of Salmonella enterica Serovars Enteritidis and Typhimurium to Chlorine-Based Oxidative Stress. J. Appl Environ Microbiol. 76:5013-5024.
- WERNICKI, A., NOWACZEK, A., and URBAN-CHMIEL, R. 2017. Bacteriophage therapy to combat bacterial infections in poultry. Virol J. 14:179.